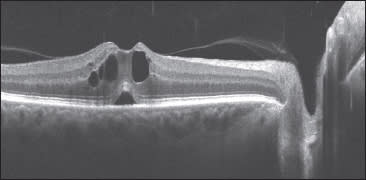
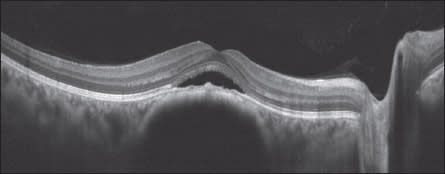

diagnosis
What SD-OCT Can Do for You: An Optometric Perspective
More optometrists are recognizing this technology's many invaluable applications.
Robert Murphy, contributing editor

Spectral domain ocular coherence tomography (SD-OCT) is rapidly becoming an incredibly necessary technology within optometry. And with good reason. (See SD-OCT Manufacturers,” below.)
Glaucoma and retinal applications were the natural initial markets for SD-OCT. These markets have grown significantly in recent years, as an increasing number of optometrists have recognized the clinical value of SD-OCT. Once they begin using this technology, many optometrists quickly come to appreciate its potentially vital role in their practice.
Recent developments and improvements in SD-OCT software and registration allow for sophisticated progression analysis, not only of glaucoma but also of age-related macular degeneration (AMD) and other retinal disease. Assessment and analysis of the retinal ganglion cell complex is now available on some SD-OCT systems. Anterior segment indications are said to be largely unexplored, an avenue for further development.
Still, the clinical capabilities of SD-OCT are already impressive. For management of longrange glaucoma or (AMD), SD-OCT has nearly become the standard of care.
At roughly $40,000 to $70,000, an SD-OCT system is a major outlay. Will the typical optometric practice use it enough to justify the cost? Optometrists who shared their experience recently said they perform SD-OCT at least two or three times daily — for billable indications, not just screening. Others offer a screening SD-OCT as an a la carte service for an out-of-pocket fee of about $25 to $50. Even with sharply reduced Medicare payments, clinicians find that the instrument can be highly remunerative.
Beyond economics, many say SD-OCT allows them to deliver a higher level of patient care than ever before. This, too, is strong motivation to adopt the technology.
A new standard of care?
Standard of care is a medicolegal concept defined as the level of care expected from comparable-level clinicians in comparable situations within the same geographical region. As optometry's scope of practice varies from one state to the next, a state's borders more or less define a practitioner's region.
Given that SD-OCT has become a near requirement among eyecare practitioners who manage and treat glaucoma, is an optometrist who is not equipped with such a system falling short of the prevailing standard of care? No, at least not yet. The technology can be considered a standard only if a large majority of optometrists in a specific region possess and regularly use it. Even as many more optometrists are investing in the technology, the many who have not yet purchased a system cannot be held to a standard that does not widely prevail.
That may change: “I can't think of anything in the office that can change the day like an SD-OCT can,” says J. James Thimons, O.D., medical director of Ophthalmic Consultants of Connecticut, in Fairfield, Conn. “I don't think that it has become the standard of care yet. I do believe that, as with automated perimetry many years ago, there will come a time when SD-OCT is the standard of care. It took about 15 years for visual fields to become the standard. I think it will take SD-OCT about five to seven years.”
| SD-OCT Manufacturers |
|---|
| • Bioptigen: www.bioptigen.com • Carl Zeiss Meditech: www.meditec.zeiss.com/us • Heidelberg Engineering: www.heidelbergengineering.com/us/ •Optovue: www.optovue.com • Topcon Medical Systems, Inc.: www.topconmedical.com |
At this time, it is difficult to envision an optometrist being held legally liable for not performing SD-OCT and perhaps missing early retinal nerve fiber layer thinning or ganglion cell loss. But that day may be coming, especially if optometrists in the region purchase the equipment and start using it regularly on patients who have glaucoma or retinal disease.

Note the focal lesion of the IS/OS, as seen via the Bioptigen SD-OCT. Adaptive Optics imaging verified that cones are missing in the lesion, and it is only about 30 microns in diameter. The pathology is suspected to be remnant of commotio retinae. PHOTO CREDIT: JOHN FLATTER, SANG HONG AND JOE CARROLL, MEDICAL COLLEGE OF WISCONSIN.
Whether an optometrist is meeting the standard of care may depend in large part on the nature of his or her practice. If glaucoma and (AMD) patients comprise a significant percentage of a practice's population, SD-OCT may already be the standard of care.
“If essentially everybody in my region were using SD-OCT and I were not, then I would have a tough argument that I was doing what I was supposed to be doing,” says Chuck Aldridge, O.D., a Burnsville, N.C., optometrist with several decades of experience in glaucoma treatment.
Others are less equivocal: As a staff O.D. at Bascom-Palmer Eye Institute in Miami, Fla., Mark Dunbar, O.D., and his colleagues routinely use SD-OCT daily. “Clinicians recognize that they couldn't practice without it,” Dr. Dunbar says. “But has it become the standard of care? I would say it has. Among optometrists who have made a decision to treat glaucoma — not dabbling, but routinely treating — I would say every one of them has an SD-OCT, without question.”
Optometric indications for SD-OCT
Anyone who has read the ophthalmic literature in recent years has no doubt been inundated by word of SD-OCT's dramatic clinical value. Product managers at ophthalmic trade shows have been happy to take doctors aside and persuade them of the indispensability of SD-OCT, not to mention its revenue potential.

Note the macular hole with cystic edema identified by Heidelberg's SD-OCT device. PHOTO CREDIT: HEIDELBERG ENGINEERING
Given this kind of buzz, many practitioners have an obvious question: Do I really need this sophisticated and expensive technology? After all, for decades optometrists and ophthalmologists alike have been diagnosing and following glaucoma with tonometry, stereo fundus photos and visual fields. Does the lack of an SD-OCT now leave you without adequate instrumentation to diagnose glaucoma and follow its changes?
Of course not. Intraocular pressures, photos and visual fields have not lost their clinical utility. Rather, the clinical value of SD-OCT lies in what it adds in terms of quantifiable diagnostic data and otherwise unobtainable images, together with progression analysis in parameters, such as retinal nerve fiber layer changes, ganglion cell loss and optic nerve cupping. SD-OCT provides an unmatched objective source of imaging and data. The quickness and ease-of-use, in addition to software upgrades, such as normative databases, make the technology especially valuable.
“With an SD-OCT, you're talking about literally being able to see microns of change that I just don't believe you can see clinically,” Dr. Dunbar says.
Glaucoma comes first to mind among SD-OCT's indications. In the past year, some SD-OCTs have introduced ganglion cell complex analysis to supplement retinal nerve fiber layer analysis.
“That's an additional piece of information that perhaps you're able to pick up much earlier than you would from a visual field or by clinically looking at the nerve,” Dr. Dunbar says.
Pseudophakic cystoid macular edema, as seen through Carl Zeiss Meditec's SD-OCT device. PHOTO CREDIT: DAVID CAMINO, O.D.
Perhaps nothing has enhanced the clinical utility of SD-OCT more than the introduction of normative databases and progression analyses for use in both glaucoma and retinal disease. A normative database allows the operator to view at a glance whether the clinical parameters in question fall within normal limits, which can be invaluable.
“It's critically important,” Dr. Aldridge says. “There is a tremendous amount of quantifiable data that comes out of one scan. And you wonder, what does this mean to me? I've captured all this data, and what I really want to know is, is it normal or not? Is it something I need to dig deeper into, or not?”
Precise registration of the optic nerve or macula from one visit to the next allows for sophisticated progression analysis through long periods. This, in turn, permits elaborate analysis of minute changes matched against a previous visit's findings.
“Spectral domain is far superior [to time domain] for the management of glaucoma because it allows you to register the position of the optic nerve,” Dr. Thimons says. “With registration, you leap into a different level of optic nerve assessment because you're comparing the exact same nerve again and again.
“With the ability to register optic nerves, you can do a glaucoma progression analysis. I really hesitate to say how I could visually do a better job myself compared to the instrument in tracking progression.”
Beyond glaucoma and macular degeneration, SD-OCT has utility in the optometric office for retinal indications, such as epiretinal membrane, macular traction and macular edema from varying causes. In addition, SD-OCT has application in the management of patients taking hydroxychloroquine. The arthritis drug is known in isolated cases to produce a so-called bull's-eye maculopathy.
Note the neurosensory detachment, as seen via Optovue's SD-OCT system. PHOTO CREDIT: OPTOVUE
“The standard of care for hydroxychloroquine has changed. We used to do 10-2 [threshold] visual fields, color vision, Amsler grid and photos,” Dr. Dunbar says. “New guidelines published last year said that traditional testing was not good enough. The new regimen calls for SD-OCT. If you don't have spectraldomain OCT, you probably have no business following patients on hydroxychloroquine.”
Anterior segment applications for SD-OCT have also recently emerged. At this early stage, such functionality primarily amounts to anterior chamber scans to assess the angle, as well as thickness measurements across the entire cornea. The latter is especially useful in detecting incipient keratoconus.
“What you see is, before you get to ectasia, [the cornea] thins,” Dr. Aldridge says. “So the SD-OCT scan will pick it up before topography will.”
SD-OCT's financial impact
The question on the mind of anyone who contemplates a sizable investment in diagnostic equipment is will I use it enough to make it financially viable? This is an especially difficult question to answer in the case of SD-OCT scans, for which Medicare reimbursements have dropped from about $120 per eye to about $40 per eye. That low level of reimbursement “has become a barrier for a lot of people,” Dr. Dunbar says.
Some clinicians have overcome this problem by acquiring a system that uses a pay-per-use model of image acquisition. Such devices are available at little or no up-front cost, making them an attractive option for the owners/doctors of small or beginning practices. The compact and portable unit does nearly everything a more expensive system can do, and many practitioners offer an SD-OCT screening for a modest out-of-pocket fee.
Other eyecare practitioners recognize that an SD-OCT can provide a sizable return on their investment based simply on the volume of patients for whom it's indicated due to patient history, signs or symptoms. Even as glaucoma remains the most prevalent indication for the device's use, SD-OCT also has clinical value in diagnosing and enabling the eyecare practitioner to follow retinal disease.
“I don't believe [optometrists] have a good sense of the volume of retina [pathology] in the practice that SD-OCT can serve,” Dr. Thimons says. “On the glaucoma side, I think they have a pretty good idea. I don't think I know the practice that can't get enough patients [to undergo the device] during a month.”
A new level of care
SD-OCT will not do away with the need for a careful fundus exam, perhaps with photos, or for visual fields and tonometry. Instead, SD-OCT provides the eyecare practitioner with additional quantifiable data that is unobtainable from other diagnostic sources.
SD-OCT technology can elevate your practice, as it is the same technology used by retina specialist, says Dr. Dunbar. “You can make the right referrals, you can diagnose early,” he says. “And at the end of the day, the patient gets better care because they're being diagnosed early, and they're getting early treatment.” OM
| Mr. Murphy is a freelance writer based in the Philadelphia area. He has spent several years reporting on the eyecare field. You can e-mail him at rmurphy2000@verizon.net. Or send comments to optometricmanagement@gmail.com. |



